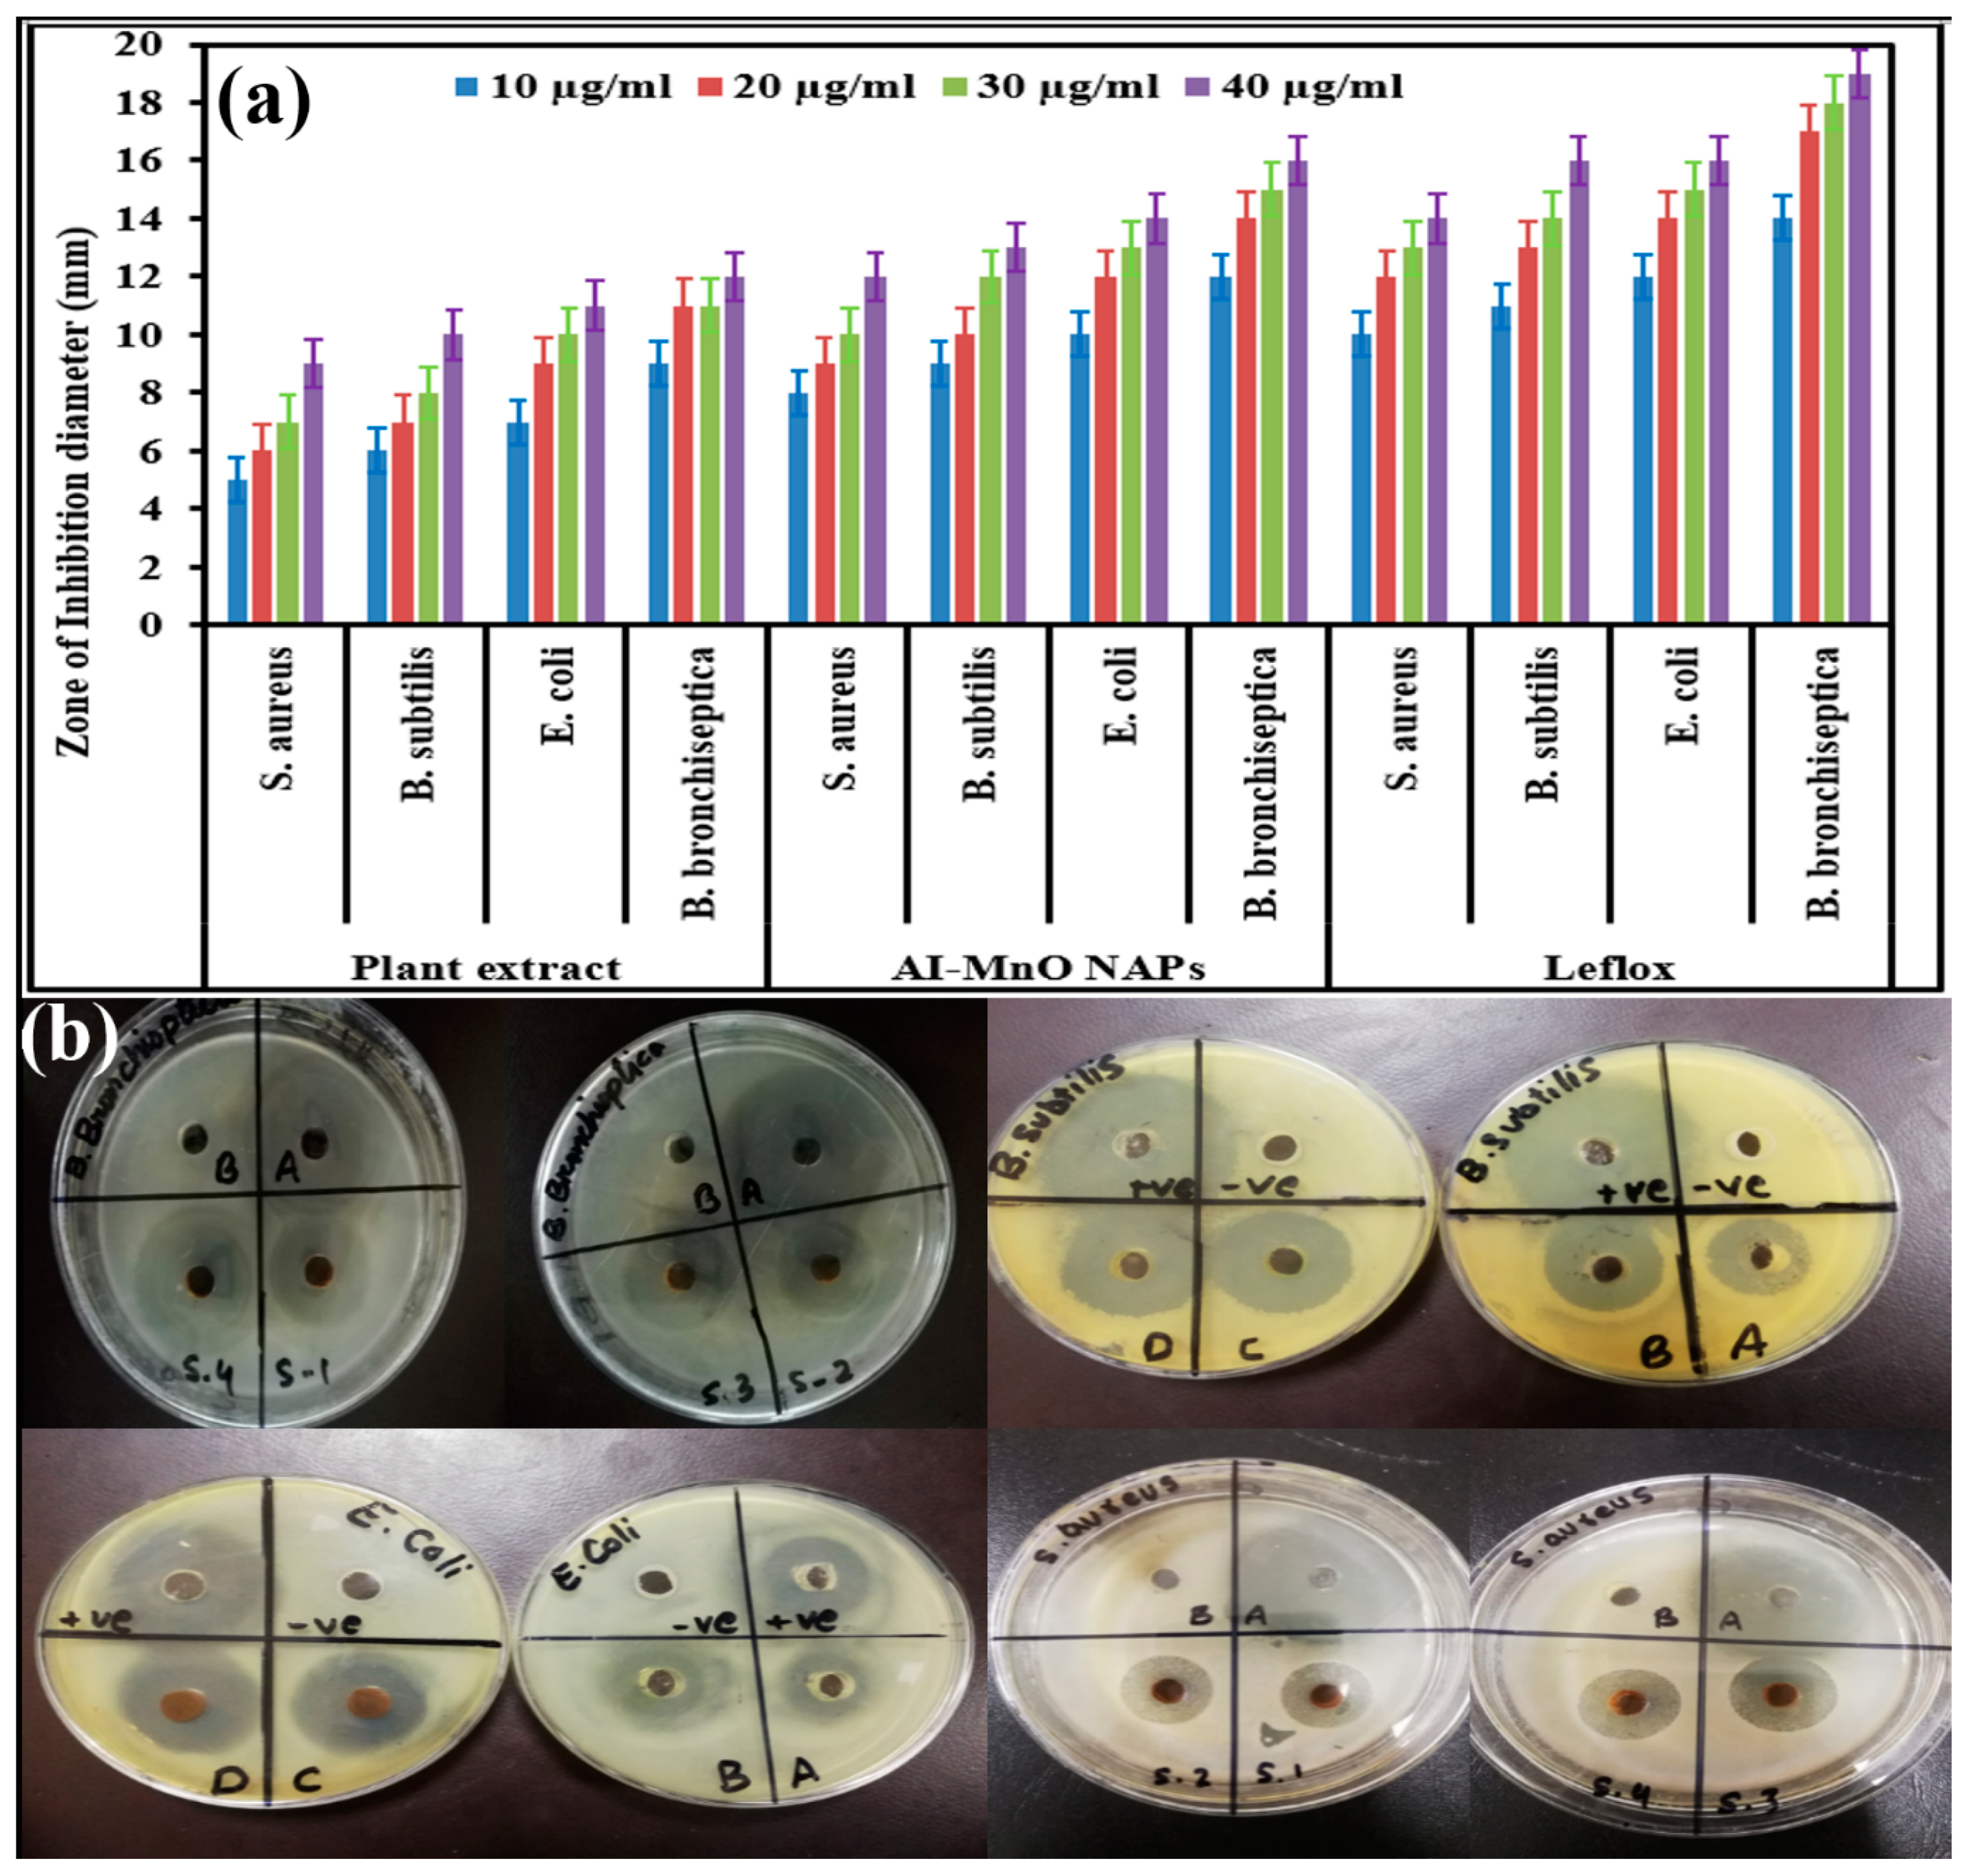
Biomolecules 10 00785 g004 Biomolecules 10 00785 g004

Green Synthesis of MnO Nanoparticles Using Abutilon indicum Leaf Extract for Biological, Photocatalytic, and Adsorption Activities
Abstract
1. Introduction
2. Materials and Methods
2.1. Chemicals
2.2. Collection of Plant Material
2.3. Plant Extract Preparation and Synthesis of AI-MnO NAPs
2.4. Characterization
2.5. Antibacterial Activity
2.6. Cytotoxicity Activity
2.7. Biocompatibility Analysis
2.8. Photocatalytic Activity Against Methylene Blue
2.9. Cr(VI) Adsorption Capacity of Synthesized AI-MnO NAPs
3. Results and Discussion
3.1. XRD Analysis
3.2. SEM Studies
3.3. EDX Analysis
3.4. UV-Visible and FTIR Analysis
3.5. Synthesis Mechanism
3.6. Antibacterial Activity
3.7. Cytotoxicity Activity Against HeLa Cells
3.8. Biocompatibility Study
3.9. Photocatalytic Activity against Methylene Blue (MB) Dye
3.10. Adsorption of Chromium(VI)
3.10.1. Effect of Adsorbent Concentration
3.10.2. Effect of Solution pH on Cr(VI) Adsorption
4. Conclusions
Author Contributions
Funding
Acknowledgments
Conflicts of Interest
References
- Ramalingam, B.; Parandhaman, T.; Das, S.K. Antibacterial effects of biosynthesized silver nanoparticles on surface ultrastructure and nanomechanical properties of gram-negative bacteria viz. Escherichia coli and Pseudomonas aeruginosa. ACS Appl. Mater. Interfaces 2016, 8, 4963–4976. [Google Scholar] [CrossRef] [PubMed]
- Cancer to Become Leading Cause of Death Worldwide by 2010. Available online: https://www.medscape.com/viewarticle/585098 (accessed on 15 December 2019).
- Khan, S.A.; Arshad, Z.; Shahid, S.; Arshad, I.; Rizwan, K.; Sher, M.; Fatima, U. Synthesis of TiO2/Graphene oxide nanocomposites for their enhanced photocatalytic activity against methylene blue dye and ciprofloxacin. Compos. Part B Eng. 2019, 175, 107120. [Google Scholar] [CrossRef]
- Abbasi, A.; Sajadi, S.M.; Amiri, O.; Hamadanian, M.; Moayedi, H.; Salavati-Niasari, M.; Beigi, M.M. MgCr2O4 and MgCr2O4/Ag nanostructures: Facile size-controlled synthesis and their photocatalytic performance for destruction of organic contaminants. Compos. Part B Eng. 2019, 175, 107077. [Google Scholar] [CrossRef]
- Hirpara, D.G.; Gajera, H.P. Green synthesis and antifungal mechanism of silver nanoparticles derived from chitin-induced exometabolites of Trichoderma interfusant. Appl. Organomet. Chem. 2020, 34, e5407. [Google Scholar] [CrossRef]
- Zangeneh, M.M.; Zangeneh, A. Novel green synthesis of Hibiscus sabdariffa flower extract conjugated gold nanoparticles with excellent anti-acute myeloid leukemia effect in comparison to daunorubicin in a leukemic rodent model. Appl. Organomet. Chem. 2020, 34, e5271. [Google Scholar] [CrossRef]
- Al-Radadi, N.S. Green synthesis of platinum nanoparticles using Saudi’s Dates extract and their usage on the cancer cell treatment. Arab. J. Chem. 2019, 12, 330–349. [Google Scholar] [CrossRef]
- Tahvilian, R.; Zangeneh, M.M.; Falahi, H.; Sadrjavadi, K.; Jalalvand, A.R.; Zangeneh, A. Green synthesis and chemical characterization of copper nanoparticles using Allium saralicum leaves and assessment of their cytotoxicity, antioxidant. Appl. Organomet. Chem. 2019, 33, e5234. [Google Scholar] [CrossRef]
- Mahdavi, B.; Saneei, S.; Qorbani, M.; Zhaleh, M.; Zangeneh, A.; Zangeneh, M.M.; Pirabbasi, E.; Abbasi, N.; Ghaneialvar, H. Ziziphora clinopodioides Lam leaves aqueous extract mediated synthesis of zinc nanoparticles and their antibacterial, antifungal, cytotoxicity, antioxidant, and cutaneous wound healing properties under in vitro and in vivo conditions. Appl. Organomet. Chem. 2019, 33, e5164. [Google Scholar] [CrossRef]
- Baharfar, R.; Zareyee, D.; Allahgholipour, S.L. Synthesis and characterization of MgO nanoparticles supported on ionic liquid-based periodic mesoporous organosilica (MgO@PMO-IL) as a highly efficient and reusable nanocatalyst for the synthesis of novel spirooxindole-furan derivatives. Appl. Organomet. Chem. 2019, 33, e4805. [Google Scholar] [CrossRef]
- Iqbal, J.; Abbasi, B.A.; Mahmood, T.; Hameed, S.; Munir, A.; Kanwal, S. Green synthesis and characterizations of Nickel oxide nanoparticles using leaf extract of Rhamnus virgata and their potential biological applications. Appl. Organomet. Chem. 2019, 33, e4950. [Google Scholar] [CrossRef]
- Ijaz, F.; Shahid, S.; Khan, S.A.; Ahmad, W.; Zaman, S. Green synthesis of copper oxide nanoparticles using Abutilon indicum leaf extract: Antimicrobial, antioxidant and photocatalytic dye degradation activities. Trop. J. Pharm. Res. 2017, 16, 743–753. [Google Scholar] [CrossRef]
- Khan, S.A.; Noreen, F.; Kanwal, S.; Iqbal, A.; Hussain, G. Green synthesis of ZnO and Cu-doped ZnO nanoparticles from leaf extracts of Abutilon indicum, Clerodendrum infortunatum, Clerodendrum inerme and investigation of their biological and photocatalytic activities. Mater. Sci. Eng. C 2018, 82, 46–59. [Google Scholar] [CrossRef] [PubMed]
- Haq, S.; Rehman, W.; Waseem, M.; Shah, A.; Khan, A.R.; Ur Rehman, M.; Ahmad, P.; Khan, B.; Ali, G. Green synthesis and characterization of tin dioxide nanoparticles for photocatalytic and antimicrobial studies. Mater. Res. Express 2020, 7, 025012. [Google Scholar] [CrossRef]
- Veeramani, H.; Aruguete, D.; Monsegue, N.; Murayama, M.; Dippon, U.; Kappler, A.; Hochella, M.F. Low-temperature green synthesis of multivalent manganese oxide nanowires. ACS Sustain. Chem. Eng. 2013, 1, 1070–1074. [Google Scholar] [CrossRef]
- Khan, S.A.; Kanwal, S.; Rizwan, K.; Shahid, S. Enhanced antimicrobial, antioxidant, in vivo antitumor and in vitro anticancer effects against breast cancer cell line by green synthesized un-doped SnO2 and Co-doped SnO2 nanoparticles from Clerodendrum inerme. Microb. Pathog. 2018, 125, 366–384. [Google Scholar] [CrossRef] [PubMed]
- Shahid, S.; Fatima, U.; Sajjad, R.; Khan, S.A. Bioinspired nanotheranostic agent: Zinc oxide; green synthesis and biomedical potential. Dig. J. Nanomater. Biostruct. 2019, 14, 1023–1031. [Google Scholar]
- Kuo, P.C.; Yang, M.L.; Wu, P.L.; Shih, H.N.; Thang, T.D.; Dung, N.X.; Wu, T.S. Chemical constituents from Abutilon indicum. J. Asian Nat. Prod. Res. 2008, 10, 689–693. [Google Scholar] [CrossRef]
- Porchezhian, E.; Ansari, S.H. Hepatoprotective activity of Abutilon indicum on experimental liver damage in rats. Phytomedicine 2005, 12, 62–64. [Google Scholar] [CrossRef] [PubMed]
- Srividya, A.R.; Dhanabal, S.P.; Jeevitha, S.; Varthan, V.V.; Kumar, R.R. Relationship between antioxidant properties and chemical composition of Abutilon indicum Linn. Indian J. Pharm. Sci. 2012, 74, 163–167. [Google Scholar] [CrossRef]
- Tripathi, P.; Chauhan, N.S.; Patel, J.R. Anti-inflammatory activity of Abutilon indicum extract. Nat. Prod. Res. 2012, 26, 1659–1661. [Google Scholar] [CrossRef]
- Abdul, M.M.; Sarker, A.A.; Saiful, I.M.; Muniruddin, A. Cytotoxic and antimicrobial activity of the crude extract of Abutilon indicum. Int. J. Pharmacogn. Phytochem. Res. 2010, 2, 1–4. [Google Scholar]
- Seetharam, Y.N.; Chalageri, G.; Setty, S.R. Hypoglycemic activity of Abutilon indicum leaf extracts in rats. Fitoterapia 2002, 73, 156–159. [Google Scholar] [CrossRef]
- Chandrashekhar, V.M.; Nagappa, A.M.; Channesh, T.S.; Habbu, P.V.; Rao, K.P. Antidiarrhoeal activity of Abutilon indicum Linn leaf extract. J. Nat. Med. 2004, 4, 12–16. [Google Scholar]
- Dsvgk, K.; Saranya, K.S.; Vadlapudi, V.; Yarla, N.S. Evaluation of anti-inflammatory and anti-proliferative activity of Abutilon indicum L. plant ethanolic leaf extract on lung cancer cell line A549 for system network studies. J. Cancer Sci. Ther. 2014, 6, 195–201. [Google Scholar]
- Bhajipale, N.S. Evaluation of anti-arthritic activity of methanolic extract of Abutilon indicum. Int. J. Ayurvedic Herb. Med. 2012, 2, 598–603. [Google Scholar]
- Rahuman, A.A.; Gopalakrishnan, G.; Venkatesan, P.; Geetha, K. Isolation and identification of mosquito larvicidal compound from Abutilon indicum (Linn.) Sweet. Parasitol. Res. 2008, 102, 981–988. [Google Scholar] [CrossRef]
- Bondre, A.V.; Akare, S.C.; Mourya, P.; Wanjari, A.D.; Tarte, P.S.; Paunikar, G.V. In vitro cytotoxic activity of leaves of Abutilon indicum linn. against ehrlich ascites carcinoma and Dalton’s ascitic lymphoma cell line. RJPP 2009, 1, 72–74. [Google Scholar]
- Paranjhape, A.N.; Mehta, A.A. A study on clinical efficacy of Abutilon indicum in treatment of bronchial asthma. Orient. Pharm. Exp. Med. 2006, 6, 330–335. [Google Scholar]
- Krisanapun, C.; Lee, S.H.; Peungvicha, P.; Temsiririrkkul, R.; Baek, S.J. Antidiabetic activities of Abutilon indicum (L.) sweet are mediated by enhancement of adipocyte differentiation and activation of the GLUT1 promoter. Evid. Based Complement. Altern. Med. 2011, 2011, 167684. [Google Scholar] [CrossRef]
- Golwala, D.K.; Patel, L.D.; Vaidya, S.K.; Bothara, S.B.; Mani, M.; Patel, P. Anticonvulsant activity of Abutilon indicum leaf. Int. J. Pharm. Pharm. Sci. 2010, 2, 66–71. [Google Scholar]
- Kumar, S.S.; Marella, S.S.; Vipin, S.; Sharmistha, M. Evaluation of analgesic and anti-inflammatory activity of Abutilon indicum. Int. J. Drug Dev. Res. 2013, 5, 1402–1407. [Google Scholar]
- Singh, H.; Du, J.; Singh, P.; Yi, T.H. Ecofriendly synthesis of silver and gold nanoparticles by Euphrasia officinalis leaf extract and its biomedical applications. Artif. Cell Nanomed. B 2018, 46, 1163–1170. [Google Scholar] [CrossRef] [PubMed]
- Iqbal, A.; Khan, Z.A.; Shahzad, S.A.; Usman, M.; Khan, S.A.; Fauq, A.H.; Bari, A.; Sajid, M.A. Synthesis of E-stilbene azomethines as potent antimicrobial and antioxidant agents. Turk. J. Chem. 2018, 42, 1518–1533. [Google Scholar] [CrossRef]
- Khan, S.A.; Rizwan, K.; Shahid, S.; Noamaan, M.A.; Rasheed, T.; Amjad, H. Synthesis, DFT, computational exploration of chemical reactivity, molecular docking studies of novel formazan metal complexes and their biological applications. Appl. Organomet. Chem. 2020, 34, e5444. [Google Scholar] [CrossRef]
- Khan, S.A.; Rasool, N.; Riaz, M.; Nadeem, R.; Rashid, U.; Rizwan, K.; Zubair, M.; Bukhari, I.H.; Gulzar, T. Evaluation of antioxidant and cytotoxicity studies of Clerodendrum inerme. Asian J. Chem. 2013, 13, 7457–7462. [Google Scholar] [CrossRef]
- Xu, X.; Gao, B.Y.; Tan, X.; Yue, Q.Y.; Zhong, Q.Q.; Li, Q. Characteristics of amine-crosslinked wheat straw and its adsorption mechanisms for phosphate and chromium (VI) removal from aqueous solution. Carbohydr. Polym. 2011, 84, 1054–1060. [Google Scholar] [CrossRef]
- Ma, C.; Sun, R.; Chen, Y.; Sun, J.; Ji, H.; Li, Y.; Yang, G. Freeze-drying preparation of MnOx/graphene nanocomposite as anode material for highly reversible lithium storage. J. Mater. Sci. 2020, 55, 5545–5553. [Google Scholar] [CrossRef]
- Manjula, R.; Thenmozhi, M.; Thilagavathi, S.; Srinivasan, R.; Kathirvel, A. Green synthesis and characterization of manganese oxide nanoparticles from Gardenia resinifera leaves. Mater. Today Proc. 2019. [Google Scholar] [CrossRef]
- Singh, R.; Mendhulkar, V.D. FTIR studies and spectrophotometric analysis of natural antioxidants, polyphenols and flavonoids in Abutilon indicum (Linn) Sweet leaf extract. J. Chem. Pharm. Res. 2015, 7, 205–211. [Google Scholar]
- Saranya, D.; Sekar, J. GC-MS and FT-IR Analyses of Ethylacetate Leaf extract of Abutilon indicum (L.) Sweet. Int. J. Adv. Res. Biol. Sci. 2016, 3, 193–197. [Google Scholar]
- Ma, Z.; Wu, T.; Li, P.; Liu, M.; Huang, S.; Li, H.; Zhang, Y.; Yao, S. A dual (colorimetric and fluorometric) detection scheme for glutathione and silver (I) based on the oxidase mimicking activity of MnO2 nanosheets. Microchim. Acta 2019, 186, 498. [Google Scholar] [CrossRef] [PubMed]
- Balakumar, V.; Ryu, J.W.; Kim, H.; Manivannan, R.; Son, Y.A. Ultrasonic synthesis of α-MnO2 nanorods: An efficient catalytic conversion of refractory pollutant, methylene blue. Ultrason. Sonochem. 2020, 62, 104870. [Google Scholar] [CrossRef] [PubMed]
- Roy, H.S.; Mollah, M.Y.; Islam, M.M.; Susan, M.A. Poly (vinyl alcohol)–MnO2 nanocomposite films as UV-shielding materials. Polym. Bull. 2018, 75, 5629–5643. [Google Scholar] [CrossRef]
- Rafique, M.; Sadaf, I.; Tahir, M.B.; Rafique, M.S.; Nabi, G.; Iqbal, T.; Sughra, K. Novel and facile synthesis of silver nanoparticles using Albizia procera leaf extract for dye degradation and antibacterial applications. Mater. Sci. Eng. C 2019, 99, 1313–1324. [Google Scholar] [CrossRef]
- Pazos-Ortiz, E.; Roque-Ruiz, J.H.; Hinojos-Márquez, E.A.; López-Esparza, J.; Donohué-Cornejo, A.; Cuevas-González, J.C.; Espinosa-Cristóbal, L.F.; Reyes-López, S.Y. Dose-dependent antimicrobial activity of silver nanoparticles on polycaprolactone fibers against gram-positive and gram-negative bacteria. J. Nanomater. 2017, 2017, 4752314. [Google Scholar] [CrossRef]
- Shu, M.; He, F.; Li, Z.; Zhu, X.; Ma, Y.; Zhou, Z.; Yang, Z.; Gao, F.; Zeng, M. Biosynthesis and antibacterial activity of silver nanoparticles using yeast extract as reducing and capping agents. Nanoscale Res. Lett. 2020, 15, 14. [Google Scholar] [CrossRef]
- Arasu, M.V.; Arokiyaraj, S.; Viayaraghavan, P.; Kumar, T.S.; Duraipandiyan, V.; Al-Dhabi, N.A.; Kaviyarasu, K. One step green synthesis of larvicidal, and azo dye degrading antibacterial nanoparticles by response surface methodology. J. Photochem. Photobiol. B 2019, 190, 154–162. [Google Scholar] [CrossRef]
- Slavin, Y.N.; Asnis, J.; Häfeli, U.O.; Bach, H. Metal nanoparticles: Understanding the mechanisms behind antibacterial activity. J. Nanobiotechnol. 2017, 15, 65. [Google Scholar] [CrossRef]
- Mickymaray, S. One-step synthesis of silver nanoparticles using Saudi Arabian desert seasonal plant Sisymbrium irio and antibacterial activity against multidrug-resistant bacterial strains. Biomolecules 2019, 9, 662. [Google Scholar] [CrossRef]
- Ogunyemi, S.O.; Zhang, F.; Abdallah, Y.; Zhang, M.; Wang, Y.; Sun, G.; Qiu, W.; Li, B. Biosynthesis and characterization of magnesium oxide and manganese dioxide nanoparticles using Matricaria chamomilla L. extract and its inhibitory effect on Acidovorax oryzae strain RS-2. Artif. Cell Nanomed. B 2019, 47, 2230–2239. [Google Scholar] [CrossRef]
- Macavei, S.G.; Suciu, M.; Craciunescu, I.; Barbu-Tudoran, L.; Tripon, S.C.; Balan, R. Hyperthermia effects on normal and tumor skin cells. Ann. Rom. Soc. Cell Biol. 2016, 21, 11–21. [Google Scholar]
- Khan, S.; Ansari, A.A.; Khan, A.A.; Abdulla, M.; Al-Obeed, O.; Ahmad, R. In vitro evaluation of anticancer and biological activities of synthesized manganese oxide nanoparticles. MedChemComm 2016, 7, 1647–1653. [Google Scholar] [CrossRef]
- Sheikhshoaie, I.; Ramezanpour, S.; Khatamian, M. Synthesis and characterization of thallium doped Mn3O4 as superior sunlight photocatalysts. J. Mol. Liq. 2017, 238, 248–253. [Google Scholar] [CrossRef]
- Khan, S.A.; Shahid, S.; Nazir, M.; Kanwal, S.; Zaman, S.; Sarwar, M.N.; Haroon, S.M. Efficient template based synthesis of Ni nanorods by etching porous alumina for their enhanced photocatalytic activities against methyl red and methyl orange dyes. J. Mol. Struct. 2019, 1184, 316–323. [Google Scholar] [CrossRef]
- Shahid, S.; Khan, S.A.; Ahmad, W.; Fatima, U.; Knawal, S. Size-dependent bacterial growth inhibition and antibacterial activity of Ag-doped ZnO nanoparticles under different atmospheric conditions. Indian J. Pharm. Sci. 2018, 80, 173–180. [Google Scholar] [CrossRef]
- Abbasi, S.A. Monitoring analytical measurements in presence of two component measurement error. J. Anal. Chem. 2014, 69, 1023–1029. [Google Scholar] [CrossRef]
- Du, Y.; Wang, L.; Wang, J.; Zheng, G.; Wu, J.; Dai, H. Flower-, wire-, and sheet-like MnO2-deposited diatomites: Highly efficient absorbents for the removal of Cr (VI). J. Environ. Sci. 2015, 29, 71–81. [Google Scholar] [CrossRef]
- Miretzky, P.; Cirelli, A.F. Cr (VI) and Cr (III) removal from aqueous solution by raw and modified lignocellulosic materials: A review. J. Hazard. Mater. 2010, 180, 1–9. [Google Scholar] [CrossRef]

© 2020 by the authors. Licensee MDPI, Basel, Switzerland. This article is an open access article distributed under the terms and conditions of the Creative Commons Attribution (CC BY) license (http://creativecommons.org/licenses/by/4.0/).
Share and Cite
Khan, S.A.; Shahid, S.; Shahid, B.; Fatima, U.; Abbasi, S.A. Green Synthesis of MnO Nanoparticles Using Abutilon indicum Leaf Extract for Biological, Photocatalytic, and Adsorption Activities. Biomolecules 2020, 10, 785. https://doi.org/10.3390/biom10050785
Khan SA, Shahid S, Shahid B, Fatima U, Abbasi SA. Green Synthesis of MnO Nanoparticles Using Abutilon indicum Leaf Extract for Biological, Photocatalytic, and Adsorption Activities. Biomolecules. 2020; 10(5):785. https://doi.org/10.3390/biom10050785
Chicago/Turabian StyleKhan, Shakeel Ahmad, Sammia Shahid, Basma Shahid, Urooj Fatima, and Saddam Akber Abbasi. 2020. "Green Synthesis of MnO Nanoparticles Using Abutilon indicum Leaf Extract for Biological, Photocatalytic, and Adsorption Activities" Biomolecules 10, no. 5: 785. https://doi.org/10.3390/biom10050785
APA StyleKhan, S. A., Shahid, S., Shahid, B., Fatima, U., & Abbasi, S. A. (2020). Green Synthesis of MnO Nanoparticles Using Abutilon indicum Leaf Extract for Biological, Photocatalytic, and Adsorption Activities. Biomolecules, 10(5), 785. https://doi.org/10.3390/biom10050785

